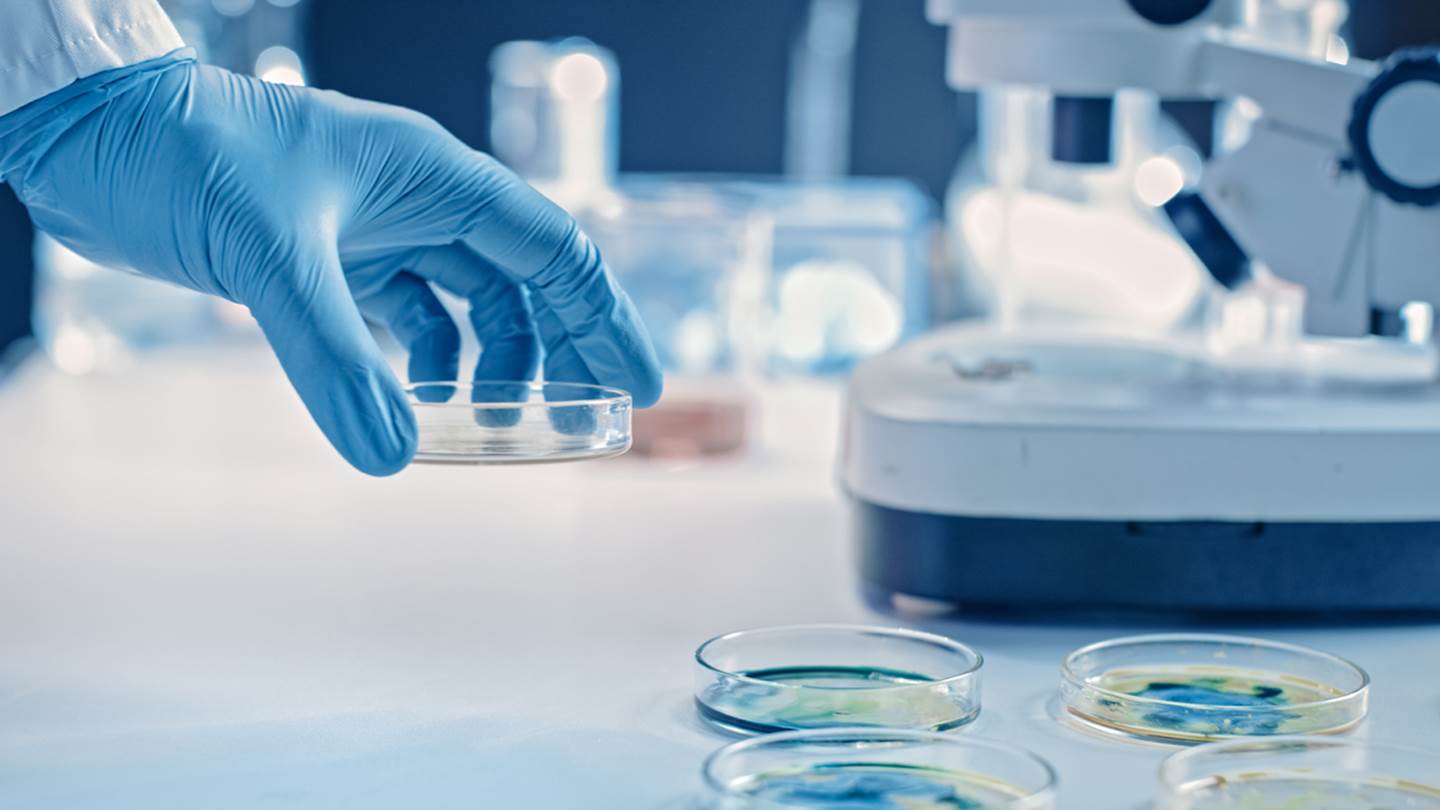
Η ελπιδοφόρα θεραπεία για τον κορονοϊό από την AbCellera

Κατά τη διάρκεια της ενημέρωσης των δημοσιογράφων τη Δευτέρα, ο γενικός διευθυντής του Παγκόσμιου Οργανισμού Υγείας (ΠΟΥ), Τέντρος Γκεμπρεγεσούς, ανέφερε ότι τις τελευταίες δύο εβδομάδες καταγράφηκαν περισσότερα νέα κρούσματα του κορονοϊού από ό,τι κατά τους πρώτους έξι μήνες της πανδημίας. Εν τω μεταξύ, λιγότερο από το 10% του παγκόσμιου πληθυσμού έχει κάνει μέχρι στιγμής τουλάχιστον μία δόση εμβολίου κατά του κορονοϊού και λιγότερο από το 5% έχει εμβολιαστεί πλήρως.
"Περιμένω ότι θα υπάρξει στις ΗΠΑ και στον Καναδά, καθώς και σε άλλες ανεπτυγμένες χώρες, μια κορύφωση της πανδημίας φέτος”, λέει ο Carl Hansen, διευθύνων σύμβουλος και συνιδρυτής της εταιρείας AbCellera, με έδρα το Βανκούβερ. "Ελπίζουμε ότι θα υποχωρήσει πολύ γρήγορα, αλλά αυτή η κορύφωση πιθανότατα δεν θα συμβεί το 2021 σε όλες τις χώρες, καθώς υπάρχουν περιοχές που είναι πολύ πίσω. Και θα συνεχίσουμε να βλέπουμε εστίες”, προσθέτει.
Την Τρίτη, η AbCellera ανακοίνωσε ότι ανακάλυψε ένα νέο υποψήφιο αντίσωμα για τη θεραπεία του κορονοϊού, που ονομάζεται "LY-CoV1404” ή "1404” για συντομία. Εργαστηριακή μελέτη, την οποία προδημοσίευσε η εταιρεία στον ιστότοπο BioRxiv, έδειξε ότι το αντίσωμα εξουδετερώνει όλες τις ανησυχητικές μεταλλάξεις του κορονοϊού που κυκλοφορούν στις Ηνωμένες Πολιτείες, συμπεριλαμβανομένου του μεταλλαγμένου στελέχους Β.1.1.7, που εντοπίστηκε για πρώτη φορά στο Ηνωμένο Βασίλειο και τώρα αντιπροσωπεύει σχεδόν το 60% του συνόλου των κρουσμάτων στις Ηνωμένες Πολιτείες.
Είναι, επίσης, αποτελεσματικό έναντι του μεταλλαγμένου στελέχους B.1.351, το οποίο εντοπίστηκε αρχικά στη Νότια Αφρική, έναντι του στελέχους P.1, το οποίο προέρχεται από τη Βραζιλία, καθώς και έναντι αρκετών άλλων μεταλλαγμένων στελεχών που έχουν εντοπιστεί.
Το πλέον ενδιαφέρον, προσθέτει ο Hansen, είναι ότι το αντίσωμα ενδεχομένως να είναι αποτελεσματικό σε αρκετά χαμηλές δόσεις ώστε να μπορεί να χορηγηθεί με μια απλή ένεση και όχι ενδοφλεβίως. Γεγονός που θα διευκόλυνε τη ευρεία διανομή του.
Ο φαρμακευτικός κολοσσός Eli Lilly, με τον οποίο συνεργάζεται η εταιρεία, πραγματοποιεί κλινικές δοκιμές με το εν λόγω αντίσωμα, στο πλαίσιο των οποίων πραγματοποιείται και μια τυφλή, τυχαιοποιημένη κλινική δοκιμή εικονικού φαρμάκου σε ασθενείς που έχουν διαγνωστεί με ήπια έως μέτρια νόσο Covid, την οποία προκαλεί ο κορονοϊός. Στόχος της θεραπείας είναι να αποτρέψει τόσο τη νοσηλεία όσο και τον θάνατο των νοσούντων.
Ακόμη και στο ενδεχόμενο νέων μεταλλάξεων, ο Hansen πιστεύει ότι το αντίσωμα "1404” θα συνεχίσει να είναι αποτελεσματικό, διότι στοχεύει σε ένα τμήμα της "πρωτεΐνης ακίδας” του κορονοϊού που σπάνια αλλάζει - καμία από τις μεταλλάξεις που κυκλοφορούν δεν έχει γενετικές αλλαγές σε αυτήν την περιοχή. Ως εκ τούτου, η εταιρεία πιστεύει ότι θα είναι επίσης αποτελεσματικό έναντι του μεταλλαγμένου στελέχους B.1.617 που κυκλοφορεί σήμερα στην Ινδία, αν και θα κάνει εργαστηριακές δοκιμές για να το επιβεβαιώσει.
"Έχουμε ακόμη δουλειά μπροστά μας προτού μπορέσουμε να το κάνουμε πραγματικότητα”, λέει ο δισεκατομμυριούχος Hansen, με περιουσία ύψους 1,6 δισ. δολαρίων. "Αλλά λόγω της ευρύτητάς του το αντίσωμα 1404, καλύπτει ουσιαστικά ότι έχουμε δει σε οποιοδήποτε κυρίαρχο στέλεχος στον κόσμο”, προσθέτει.
Τα αντισώματα είναι πρωτεΐνες που παράγονται από το ανοσοποιητικό σύστημα για να προσβάλλουν βακτήρια, ιούς ή άλλους πιθανούς νοσογόνους παθογόνους παράγοντες. Όμως δεν είμαστε όλοι το ίδιο: Όταν εκτίθενται στην ίδια ασθένεια διαφορετικά άτομα, θα παράγουν διαφορετικά αντισώματα, μερικά από τα οποία λειτουργούν καλύτερα από άλλα. Η AbCellera εκμεταλλεύεται το γεγονός αυτό και χρησιμοποιεί την τεχνολογία της προκειμένου να εντοπίσει κυρίως αυτά που είναι πιο αποτελεσματικά, τα οποία στη συνέχεια μπορούν να χορηγηθούν σε ασθενείς για την αντιμετώπιση ασθενειών.
Αντίσωμα νέας γενιάς
Το αντίσωμα "1404” ξεκίνησε να υποβάλλεται σε κλινικές δοκιμές σχεδόν ένα χρόνο μετά την έναρξη κλινικών δοκιμών για την πρώτη θεραπεία αντισωμάτων κατά του κορονοϊού που ανέπτυξαν η AbCellera και η Lilly, του bamlanivimab. Το συγκεκριμένο αντίσωμα ανακαλύφθηκε με τη χρήση της τεχνολογίας της AbCellera, η οποία εξέτασε το αίμα χιλιάδων ανθρώπων που είχαν αναρρώσει από τη νόσο Covid ώστε να εντοπίσει τα καλύτερα υποψήφια αντισώματα ως θεραπεία.
Το Bamlanivimab έλαβε άδεια επείγουσας χρήσης από τον αμερικανικό Οργανισμό Τροφίμων και Φαρμάκων (FDA) τον Νοέμβριο του 2020, ενώ έλαβε ακόμη μια άδεια επείγουσας χρήσης σε συνδυασμό με ένα άλλο αντίσωμα που συνανέπτυξε η Lilly και ονομάζεται etesevimab. Οι κλινικές δοκιμές έδειξαν ότι η συνδυαστική θεραπεία απέτρεψε τις νοσηλείες και τους θανάτους από κορονοϊό κατά 87% σε ασθενείς υψηλού κινδύνου.
Τον προηγούμενο μήνα, η Lilly ανακοίνωσε έσοδα 810 εκατ. δολαρίων από τα αντισώματα κατά του κορονοϊού για το πρώτο τρίμηνο του 2021. "Αυτό το αντίσωμα έχει χρησιμοποιηθεί ήδη είτε μόνο του είτε συνδυαστικά για να βοηθήσει περισσότερους από 500.000 ανθρώπους στις ΗΠΑ”, λέει ο Hansen. "Αυτό σημαίνει ότι σώθηκαν περισσότερες από 10.000 ζωές. Είναι μακράν η ευρύτερα χρησιμοποιούμενη θεραπεία αντισωμάτων κατά της Covid-19”, προσθέτει.
Δυστυχώς, στις αρχές του 2021, διαπιστώθηκε ότι το bamlanivimab δεν ήταν πολύ αποτελεσματικό έναντι ορισμένων μεταλλάξεων του κορονοϊού, συμπεριλαμβανομένων των στελεχών B.1.526, που εντοπίστηκε για πρώτη φορά στη Νέα Υόρκη, και B.1.426/429, που εντοπίστηκε στην Καλιφόρνια. (Είναι, πάντως, αποτελεσματικό έναντι του στελέχους B.1.1.7.). Ως αποτέλεσμα, τον Απρίλιο, η Lilly απέσυρε το αίτημά της για άδεια επείγουσας χρήσης του bamlanivimab από μόνου του ως θεραπεία κατά του κορονοϊού, που πλέον χρησιμοποιείται μόνο σε συνδυασμό με το etesevimab.
Η έρευνα για το αντίσωμα "1404”, όπως λέει ο Hansen, ξεκίνησε τον Ιανουάριο του 2021, όταν νέες μεταλλάξεις, ιδίως το στέλεχος Β.1.351, άρχισαν να προκαλούν αυξανόμενο αριθμό κρουσμάτων. "Τότε αποφασίσαμε να εφαρμόσουμε ξανά την τεχνολογία μας για να ανακαλύψουμε αυτό που πιστεύουμε ότι θα μπορούσε να είναι ένα αντίσωμα νέας γενιάς”, λέει ο Hansen. "Αυτό παρουσίασε τον τέλειο συνδυασμό αποτελεσματικότητας έναντι κάθε μετάλλαξης που κυκλοφορεί εκεί έξω, και εξαιρετικής δραστικότητας”, τονίζει.
Κατά τη διάρκεια της κλινικής δοκιμής, το "1404” θα δοκιμαστεί τόσο μόνο του όσο και σε συνδυασμό με το αντίσωμα bamlanivimab και με το Vir-7831, ένα αντίσωμα που ανέπτυξαν η GSK και η Vir Biotechnologies.
Ο Hansen, πάντως, είναι ιδιαίτερα ενθουσιασμένος με τα αποτελέσματα χρήσης του "1404” από μόνου του, όπως λέει, διότι είναι ιδιαίτερα δραστικό, που σημαίνει ότι ακόμη και χαμηλότερες δόσεις του φαρμάκου θα μπορούσαν να είναι πολύ αποτελεσματικές στην πρόληψη σοβαρής νόσησης από τον κορονοϊό.
Αυτό είναι σημαντικό για περιοχές του πλανήτη που δεν διαθέτουν ανεπτυγμένες ιατρικές υποδομές, διότι επί του παρόντος οι θεραπείες αντισωμάτων που κυκλοφορούν ή βρίσκονται σε φάση κλινικών δοκιμών απαιτούν την ενδοφλέβια έγχυση στους ασθενείς. Το αντίσωμα "1404”, από την άλλη πλευρά, "παρέχει την προοπτική να χορηγείται με μια υποδόρια ένεση, αντί ενδοφλεβίως”, εξηγεί ο Hansen. "Το γεγονός αυτό αλλάζει τα δεδομένα του παιχνιδιού. Εάν επιτευχθεί αυτό, η ευκολία με την οποία θα μπορεί να χορηγείται κατεβάζει τον πήχη των απαιτήσεων για την εφοδιαστική αλυσίδα”, προσθέτει.
Ένα αντίσωμα κατά του κορονοϊού που θα μπορεί να χορηγηθεί ενέσιμα, θα μπορούσε να αποτελέσει "όπλο” ζωτικής σημασίας για πολλές χώρες χαμηλού εισοδήματος, ορισμένες εκ των οποίων ενδεχομένως δεν θα παραλάβουν εμβόλια μέχρι τα τέλη του τρέχοντος έτους ή πιθανότατα και μέσα στο 2022. Ακόμη, όμως, και αν απαιτείται τελικά η ενδοφλέβια έγχυσή του, ο Hansen επισημαίνει ότι η εταιρεία του είναι έτοιμη να προσφέρει τη θεραπεία σε όσους την χρειάζονται. "Υπάρχει μια πολύ ισχυρή δέσμευση από την πλευρά μας να προσπαθήσουμε να προσφέρουμε αυτές τις θεραπείες σε ασθενείς που τις χρειάζονται το συντομότερο δυνατό”, λέει χαρακτηριστικά.
Ένας εκπρόσωπος της Lilly δήλωσε στο Forbes την προηγούμενη εβδομάδα ότι η εταιρεία βρίσκεται σε συζητήσεις με την κυβέρνηση της Ινδίας για να παράσχει θεραπείες αντισωμάτων στη χώρα όταν οι ρυθμιστικές αρχές της δώσουν τη σχετική άδεια.
Για τον Hansen, η ανάπτυξη μιας πρώιμης θεραπείας κατά του κορονοϊού και στη συνέχεια μιας θεραπείας νέας γενιάς σε διάστημα μόλις ενός έτους, καταδεικνύει τις δυνατότητες που παρέχει η τεχνολογία της εταιρείας του στο να συνδράμει τους πελάτες της να εντοπίσουν γρήγορα αποτελεσματικές θεραπείες. "Αυτά είναι μόνο 2 από τα 100 προγράμματα που τρέχουμε στην AbCellera”, λέει. "Προσπαθούμε να κάνουμε το ίδιο για την αντιμετώπιση του καρκίνου, μολυσματικών ασθενειών, της παχυσαρκίας, του διαβήτη - σε όλους τους τομείς. Ελπίζω και εκτιμώ ότι αποτελεί απλώς μια γεύση από αυτά που θα ακολουθήσουν στο μέλλον”, καταλήγει.
Από: Capital.gr